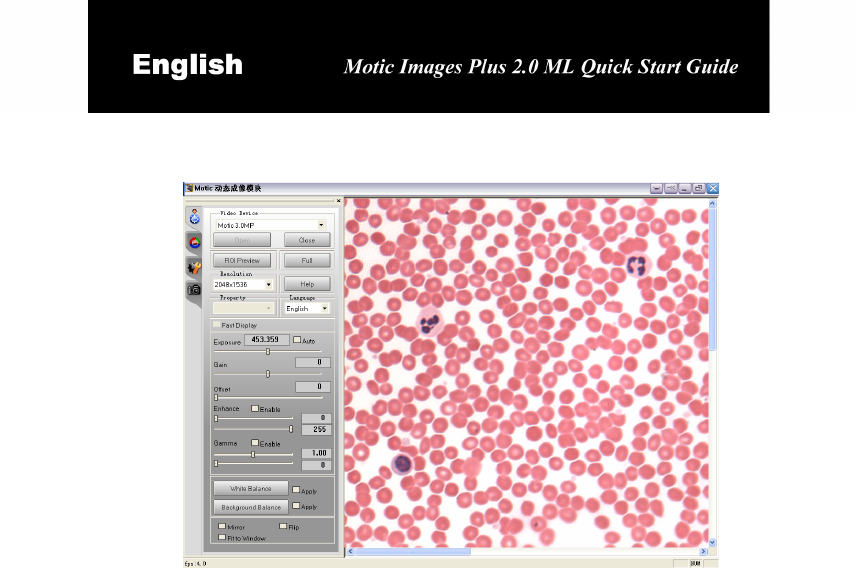

2.0ML_En Motic_Images_Plus_for_PC Motic Images Plus For PC
User Manual: Motic_Images_Plus_for_PC
Open the PDF directly: View PDF ![]() .
.
Page Count: 28


Contents
Installing the Driver .........................................................................4
Motic Images Plus 2.0 ML .............................................................13
Precise Calibration ........................................................................13
Capturing Images and Video ........................................................18
Taking Measurements ...................................................................20
Customizing Your Settings ...........................................................21
Adding Sound to Your Files..........................................................23
How to Play Sound ........................................................................24
How to Combine Images...............................................................24
Note:
The intention of this guide is to provide quick instructions to key tasks
of the Motic Images Plus software. If more detail is needed or what
you are looking for is not contained in this guide, please consult the
documentation that comes with your microscope or visit our website
http://www.motic.com.

1
Installing the Software
Before installing Motic Images Plus 2.0 ML, please read this chapter carefully,
and perform setup by following the step-by-step instructions.
Preparation for Software Installation
1. Get your Motic microscope ready, and check that the USB cable of
microscope is not connected to the USB port of the computer.
2. Microscope is powered up.
Installing the Software
Follow the instructions outlined below to install Motic Images Plus 2.0 ML
(images from Windows XP, similar processes for Windows 2000).
Insert the CD-ROM into your CD-ROM
drive and the setup wizard appears
automatically.
The Motic Images Plus 2.0 ML Installer
prompts Setup being processed.
Get ready for installation as the installer
informs and click “Next”.

2
To install Motic Images Plus 2.0 ML, you
must accept all the terms of the Software
License Agreement. If you agree, click “Yes”
to continue. If you do not, click “No” and the
installation will be cancelled.
Please fill in the blanks with your name and
company name before continuing with the
installation process. Click “Next”.
The Choose Destination Location dialog box
will appear. Accept the default destination
path “C:\ Program Files\ Motic\ Motic Images
Plus 2.0” or click “Browse” to select your own
path. Then click “Next”.

3
Select one of the 3 Setup types to install;
before file copying starts, you may review
or change the settings by clicking “Back”.
Begin program installation by clicking
“Next”.
Accept the default program folder “Motic”,
or specify a different folder by entering
your own folder name or selecting from an
existing folder and click “Next”.
Copying of program files begins. (If you
wish, you can choose to install the Adobe
reader and DirectX9 before the copying of
the program files starts).

4
When all the program files have been
copied to your computer, click “Finish” .It is
highly recommended that you restart your
computer.
Installing the Driver
Installing the Driver in Windows XP:
Ensure the Moticam350 (2E) device is
connected to the computer. The “Found
New Hardware Wizard” will then appear.
Select “Install from a list or specific
location (Advanced)”, and click “Next”.
Select the item “Include this location in the
search”, and then insert the CD. Click
“Browse” to select the driver.

5
Locate the “2E” folder under “Driver” in the
CD-ROM (or select the corresponding
driver according to the instructions on the
CD case, or see the chart below) and click
“OK”.
Device Interface Driver
USB 2.0 M230
Camera 3 PAL
USB 1.0 M210
USB 2.0 M230
Camera 3 NTSC
USB 1.0 AD640
MC1001/MC2001/
MC 3001
USB 2.0
Motic MC
Camera
V3
MC1001/MC2001/
MC3001/1002/2002
(for Vista)
USB 2.0
Motic
USB2
Camera
MC352 USB 1.0 MC352
MC352+ USB 1.0 MC352+
Note: If you use M230, please ensure that:
1. The driver is installed under Windows
XP or Windows 2000 + SP4 operating
system;
2. USB 2.0 driver and DirectX9.0b (or
higher version) have been correctly
installed.

6
Please confirm the destination path, and
click "Next".
Click “Continue Anyway” to continue.
Files will be copied to your computer.

7
Click "Finish".
Installing the Motic CapL3 Driver
(If you have not yet purchased a capture card from us, such as L311, L312, L320
etc, please skip the following text.)
Left is the installation location of the
MoticCap L3xx, the PCI slot, to which the
contact footing of the said card is to be
inserted.
Press the card down with the input sockets
plate attached to the sockets panel (usually
at the back) of your computer.

8
The “Found New Hardware Wizard” will
then appear. Select “Install from a list or
specific location (Advanced)”, and click
“Next”.
Select the item “Include this location in the
search”, and then insert the CD. Click
“Browse” to select the driver.
Locate the “CapL3” folder under “Driver” in
the CD-ROM and click “OK”.

9
Please confirm the destination path, and
click "Next".
Click “Continue Anyway” to continue.
Files will be copied to your computer.

10
Click "Finish".
The “Found New Hardware Wizard” will
then appear. Select “Install from a list or
specific location (Advanced)”, and click
“Next”.
Please confirm the destination path, and
click "Next".
Click “Continue Anyway” to continue.

11
Click "Finish".
The “Found New Hardware Wizard” will
then appear. Select “Install from a list or
specific location (Advanced)”, and click
“Next”.
Please confirm the destination path, and
click "Next".

12
Click “Continue Anyway” to continue.
Files will be copied to your computer.
Click "Finish".
Restart your computer by clicking “Yes”.

13
Motic Images Plus 2.0 ML
Motic Images Plus 2.0 ML is a multi-media software offered by Motic China
Group Co., Ltd. It is especially designed for individual users and provides
advanced and easy-to-use functions for editing, analyzing and measuring
images. The Motic Images Plus 2.0 ML interface comes in two styles: Plus style
and Standard style. The default style is Standard style. You may change the style
by clicking the Setting button from the toolbar and selecting the “Interface”
tab from the popup “Settings” dialog box to specify a style. Then, restart the
software to display it in the selected style.
Precise Calibration
Calibration is a very important step to be taken before using the Motic Images
Plus 2.0 ML measuring system as it will ensure the accuracy of the system’s
measurements.
For Plus style, directly click the corresponding buttons on the Measure tool bar to
conduct calibration operation; for Standard style, click on the drop-down arrow at
the right of the Calibration button on the Measure tool bar to display the following
drop-down menus.
Plus style Standard style
Select the Calibration Wizard command to display the Calibration Wizard window.
To select a calibration method, click on the corresponding tab.
Motic Images Plus 2.0 ML provides three calibration methods, Calibrate with
Circle, Calibrate with Scale Cross and Calibrate with Scale Line. The following
images are taken from Standard style, Plus style images are similar.

14
1. Calibrate with Calibration Circle
( i ) To calibrate with a calibration circle,
select the Calibration Wizard command to
display the Calibration Wizard window. Click
on the Calibrate with Calibration Circle tab
to display the corresponding panel.
Click “Load Image” to display the Open
Image files dialog box from which calibration
circles may be selected for calibration. Click
“Open’’ to load the selected image.
( ii ) Confirm the objective lens used to
capture the selected image, then input the
diameter of the calibration circle. Click
“Calibration” to complete the calibration
process.
Note:
Use the appropriate calibration circle slide and magnification suited to your
microscope.
( iii ) The Save Sign dialog box will display
after clicking "Calibration". Click "Save" in
the dialog box to save the calibration results
and use them for measuring.
( iv ) When calibration is complete, click “Close” to close the Calibration Wizard
window.

15
2. Calibrate with Scale Cross
( i ) To calibrate with a scale cross, select
the Calibration Wizard command to display
the Calibration Wizard window. Select the
Calibrate with Scale Cross tab to display the
corresponding panel.
Click on “Load Image” to display the Open
Image files dialog box from which scale
crosses may be selected for calibration.
Click “Open” to load the selected images.
( ii ) When an image is loaded, a circle will
appear on it. Modify its color by clicking the
Circle Color button to display the
Color Palette where a color for the circle
may be selected.
First, place the center of the circle (set as
"O") in the middle of the scale cross. Next,
place a point (set as "A") that is horizontal
with the center of the circle on the horizontal
line and place a point (set as "B") that is
vertical with the center of the circle on the
vertical line. The magnifier window under the
image window will help users accurately
place the points.
Confirm the objective lens used to capture
the selected image and then input the actual
length of "OA" in the "Width" bar and the
actual length of "OB" in the "Height" bar.
Click “Calibration” to complete the
calibration process.

16
( iii ) The Save Sign dialog box will display
after clicking "Calibration". Click "Save" in
the dialog box to save the calibration results
and use them for measuring.
( iv ) When calibration is complete, click “Close” to close the Calibration Wizard
window.
3. Calibrate with Scale Line
( i ) To calibrate with a scale line, select the
Calibration Wizard command to display the
Calibration Wizard window. Select the
Calibrate with Scale Line tab to display the
corresponding panel.
First, select the Horizontal tab to load
horizontal scale lines. Click “Load Image” to
display the Open Image files dialog box from
which horizontal lines may be selected for
calibration. Click “Open” to load the selected
lines.
( ii ) Next, select the Vertical tab to load
vertical scale lines. Click “Load Image” to
display the Open Image files dialog box from
which vertical lines may be selected for
calibration. Click “Open” to load the selected
lines.

17
( iii ) When the image is loaded, a line will
appear on it. Modify its color by clicking the
Line Color button to display the
Color Palette where a color for the line may
be chosen.
Drag the two ends of the line (set as "A" on
the horizontal line and as "B" on the vertical
line) to two different scales. The magnifier
window under the image window will help
users accurately place the points.
Confirm the objective lens used to capture
the selected images and then input the
actual length of "A" in the "Width" bar and
the actual length of "B" in the “Height” bar.
Click “Calibration’’ to complete the
calibration process.
( iv ) The Save Sign dialog box will display
after clicking "Calibration". Click "Save" in
the dialog box to save the calibration results
and use them for measuring.
( v ) When calibration is complete, click “Close” to close the Calibration Wizard
window.

18
Capturing Images and Video
1. When Motic Images Plus 2.0 ML is run, the following workspace will
display:
Plus style Standard style
2. Click the Capture button (pointed out by the red arrow) on the
toolbar.
Plus style
Standard style

20
Taking Measurements
Note:
First, make sure that your system has been properly calibrated prior to taking any
measurements.
Measuring
1. Select any of the Measurement tools by clicking on the corresponding button
on the Measure tool bar.
Plus style
Standard style
2. From the Measure Control Panel, select the magnification of the objective
lens used. Click the arrow to display the drop down list of objective lenses.
3. Move the cursor onto the image window and click and drag the mouse over
the area / distance to be measured. Change the measurements by clicking
and dragging the mouse on the defined area.
4. Click the right mouse button on another part of the image to display a
shortcut menu. Select “Freeze” or “Lock” to save the measurements.
Note: Measurements may be unlocked, but to cancel the freeze status, the Undo
command must be selected.
Erasing a Measurement
To erase a measurement, apply the Undo command of Edit menu before saving
an image file.

21
Customizing Your Settings
Configuring your measurement settings
1. By clicking the Measure tab on the Control Panel, measurement settings may
be customized.
Plus style
Standard style
The measurement units and accuracy parameters (how may digits to display
after the decimal point) may also be set here.
2. After performing a measurement, click the right mouse button to display a
shortcut menu where, by selecting the Unit command, the measurement units
may be changed. If the Properties command is selected, a dialog box will
appear which allows users to change the measurement data colors and line
properties.

22
Configuring your image and video capture settings
Click the Setting button in the Plus Style or the Setting button in the
Standard Style to display the following dialog boxes:
Plus style Standard style
Here, define the size of the images to be captured, how often to capture a frame,
and other image and video properties.

23
Adding Sound to Your Files
Note:
To add sound to images, a microphone and a sound card with a microphone
input jack are needed, as well, files must be saved in SFC format (default).
1. Select the Audio tab on the Control Panel and click the “Add audio to
current image” button. Click the left mouse button on the image and a
frame will appear.
Plus style Standard style
Click the “Record” button and the Record dialog box appears. Click the record
button on this dialog to begin recording.
2. Click the “Stop” button to stop recording.

24
How to Play Sound
1. Select the Audio tab on the Control Panel
and clickthe Playlist button to display the
Playlist dialog box.Click the right mouse button
and select the Add command to add sound files
to the list.
2. Click the “Play” button and the sound files will be played in turn.
Plus style
Standard style
How to Combine Images
The following images are taken from Standard style, Plus style images are
similar.
1. Click the Album button to display the Album window. Next, click the
“Amalgamation” tab to display the corresponding panel.

25
2. Click and drag the pictures to be
combined into the Amalgamation panel.
Click the Amalgamation button and select
an amalgamation method to combine
them. The combined picture will then
appear in the preview window.
3. Or select the pictures to be combined
and click the right mouse button. Select
the Amalgamation command from the
shortcut menu and select a method to
combine them. The combined picture will
then appear in the preview window.

www.motic.com
©1999-2007 Motic China Group Co., Ltd. All rights reserved.
Motic is a registered trademark and service mark of Motic China Group Co., Ltd.
Microsoft, Windows and the Windows logo are registered trademarks of Microsoft Corporation.
All other trademarks are the property of their respective owners.
Design Change: The manufacturer reserves the right to make changes in instrument design in accordance with scientific and
mechanical progress, without notice and without obligation.
1300901105981 2007.10.23
Motic China Group Co., Ltd.
Microscopes